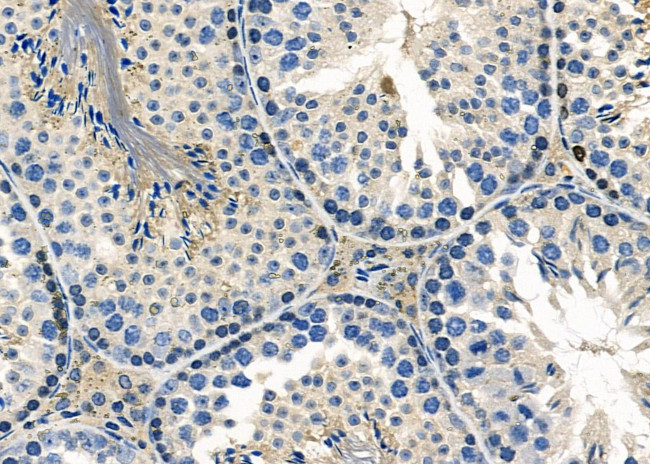
Herpes Simplex Virus Type 1 (strain 17) Antibody in Immunohistochemistry (Paraffin) (IHC (P))

Search
Invitrogen
Herpes Simplex Virus Type 1 (strain 17) Polyclonal Antibody
{{$productOrderCtrl.translations['antibody.pdp.commerceCard.promotion.promotions']}}
{{$productOrderCtrl.translations['antibody.pdp.commerceCard.promotion.viewpromo']}}
{{$productOrderCtrl.translations['antibody.pdp.commerceCard.promotion.promocode']}}: {{promo.promoCode}} {{promo.promoTitle}} {{promo.promoDescription}}. {{$productOrderCtrl.translations['antibody.pdp.commerceCard.promotion.learnmore']}}
图: 1 / 2
Herpes Simplex Virus Type 1 (strain 17) Antibody (PA5-103292) in IHC (P)


Please note: We are reviewing Western blot images included in the antibody testing data in our catalog, including those provided by third parties. Unless expressly labeled or annotated as “raw-unedited”, Western blot images included in the antibody testing data in our catalog may have been edited, optimized or otherwise adjusted for presentation.
产品信息
PA5-103292
种属反应
宿主/亚型
分类
类型
抗原
偶联物
形式
浓度
规格
纯化类型
保存液
内含物
保存条件
运输条件
RRID
产品详细信息
Antibody detects endogenous levels of total KR2_HHV11.
靶标信息
HSV is a member of the herpes virus family (Herpesviridae), Herpes simplex virus types 1 and 2 (HSV-1 and HSV-2), are ubiquitously contagious to humans. Also known as Human herpes virus 1 and 2 (HHV-1 and -2), respectively, HSV-1 strains produce cold sores, while HSV-2 produce most genital herpes. They can be spread when an infected person is producing and shedding the virus. The virion form of herpes viruses consists of a relatively large double-stranded, linear DNA genome encased within the capsid and wrapped in the viral envelope. The different HSV strains carry over 70 open reading frames (ORFs). HSV has been linked to Alzheimer's disease.
仅用于科研。不用于诊断过程。未经明确授权不得转售。
篇参考文献 (0)
生物信息学
蛋白别名: Herpes; Herpes Simplex; Herpes Simplex 1; Herpes Simplex I; herpes simplex virus 1; Herpes Simplex Virus Type 1; Herpes Virus; HHV; HSV; HSV Type 1; HSV1; KITH_HHV1S